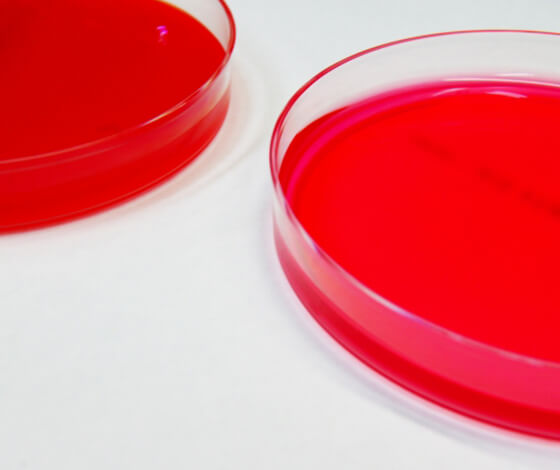
Hygiene Assessment and Rapid Hygiene Testing

- HOME
- Bacteriological Testing
Invisible Threats Require Reliable Testing —
Bacteriological Testing for Peace of MindBacteria
We offer bacteriological testing services to verify hygiene conditions in households and food
preparation areas, evaluate cleanliness in public facilities such as civic halls, and support hygiene
management in special care facilities.
Bacteriological testing is valuable not only where it is legally required, but also for voluntary safety
verification, hygiene improvement, and ongoing facility maintenance.

General Bacteria Testing
General bacteria are widely present in rivers, soil, food, air, and even the human body. While most are non-pathogenic, contaminated water tends to contain elevated levels of general bacteria, making this test a useful indicator of water contamination.

E. coli Testing
E. coli is a representative bacterium found in animal feces and is not normally detected in tap water. Because the presence of E. coli serves as an indicator of fecal contamination, periodic testing is required under the Water Supply Act.

Legionella Bacteria Testing
Facilities such as swimming pools, public baths, and hot springs, as well as equipment including cooling towers, humidifiers, and fountains, require testing to prevent infections caused by Legionella bacteria. For facilities visited by many people, Legionella bacteria testing is an essential component of thorough hygiene management. Testing details are defined in the Legionella Prevention Guidelines, and we will recommend the appropriate timing and frequency based on your specific requirements.

Hygiene Assessment and Rapid Hygiene Testing
This testing determines whether environments requiring hygienic conditions — such as food manufacturing plants, restaurant kitchens, kindergartens, and nurseries — are free from bacterial contamination. By swabbing surfaces such as cooking utensils, production lines, and door handles with a dedicated sampling kit, it is possible to quickly assess the level of bacterial contamination. Test results can also be used to review and improve cleaning methods and frequency.
Enteric Bacteria Testing
This testing verifies whether personnel who frequently come into direct contact with water supply equipment — such as those working in food manufacturing plants and restaurant kitchens — are carriers of pathogenic bacteria. If a carrier performs tasks such as cleaning a water storage tank, bacteria-related contamination of the drinking water supply could lead to the spread of infectious disease among facility users. As part of preventive hygiene management, we recommend testing at the time of hiring and when personnel are assigned to relevant duties, followed by periodic testing several times per year.

Settled Bacteria & Airborne Bacteria Testing
Testing for settled bacteria and airborne bacteria is an effective means of monitoring hygiene levels in public facilities such as schools, and in common areas of buildings and condominiums. Test results can serve as useful indicators for measures such as mold prevention on interior walls, improvements to cleaning practices, and optimization of HVAC systems. Regular testing is recommended, as it contributes to user confidence and facility safety.


